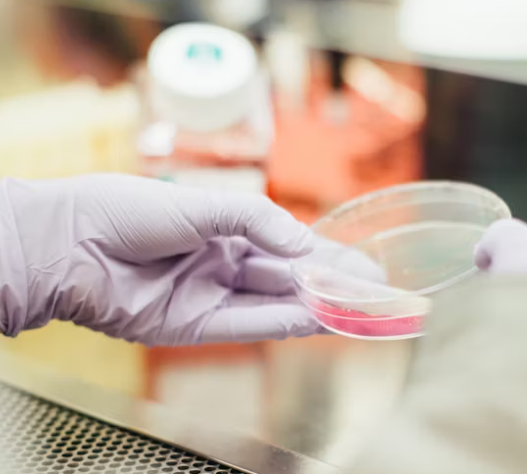

표적 항암치료는 발암을 유발하는 특정세포만 선택적으로 공격해서 항암치료는 하는 것으로, 이전의 일반 항암치료에 비해서 고통이 작은 것으로 알려진 치료방법입니다. 의학이 점점 발전하고 암환자 생존율도 이전에 비해서 많이 늘어나고 있는데요. 완치할 수는 없을지라도 표적 항암치료를 통해서도 진행을 늦추면서 생존기간을 늘릴 수 있다는 장점이 있습니다.



표적 항암치료
표적 항암치료가 모든 암환자에게 적용이 되는 치료법일까요?
표적 항암치료는 특정 돌연변이 유전자 또는 표적이 되는 단백질이 있어야만 치료가 가능한 것으로 알려져 있는데요. 그렇기 때문에 암환자라도 정확한 조직 검사를 통해서 살펴보았을 때 위의 사항에 해당되지 않으면 표적 항암치료를 할 수 없습니다.



표적항암제
표적항암제가 효과가 좋은 것은 사실이지만 가격이 비싼 것이 부담이 되고 있었습니다. 대표적인 표적항암제인 잴코리의 경우 1정당 거의 17만 원의 가격을 형성하고 있습니다.
표적항암제가 비급여 대상이라서 그 부담이 본인에게 돌아간다는 것이 부담이 아닐 수 없습니다.
그러나 최근 면역항암제와 표적항암제를 동시에 사용하는 병용요법이 건강보험 적용대상이 될 것이라는 발표가 있었습니다. 정확한 보험적용 범위에 대해서는 나와봐야 알겠지만 암환자가 늘어나고 치료법도 계속 개발이 되고 있는 현 상황에서 비용에 대한 국민의 부담도 점점 적어져야 한다고 생각합니다.
또한 국내 뿐 아니라 세계적으로 제약회사들이 표적항암제의 개발을 앞다투어하고 있는 상황이기에 앞으로 비교적 저렴한 가격에 표적 항암치료를 받을 수 있는 기회가 늘어나리라는 예상을 해봅니다.



표적 항암치료의 또 한가지 아쉬운 점을 말하자면 내성인데요.
이 경우에 특정 세포를 표적으로 치료하게 되는 것이기 때문에 같이 있던 다른 성질의 암세포까지 이 표적항암제에 대해 내성이 생기게 되는 것입니다. 이를 극복하고자 하는 연구도 계속해서 진행이 되고 있으니, 이점도 차차 보완이 될 것이라는 생각이 듭니다.
하지만, 국내 뿐만 아니라 전 세계적으로 제약. 바이오회사들이 표적 항암치료제의 시장에 앞다투어 뛰어들고 개발하고 있으며 기술을 더해 새로운 형태의 세포치료제 개발에 나서고 있으니 표적 항암치료를 받을 수 있는 기회가 넓어지고 있습니다.

암이라는 병이 이전에 비해 발병률도 높고 조기에 발견된다면 치료할 수 있는 가능성과 생존율도 높아지고 있습니다. 표적 항암치료라는 좋은 기술이 개발이 되고 앞으로도 더 좋은 기술이 개발을 기대하면서 인류가 암이라는 병으로부터 자유로워지면 좋겠습니다.